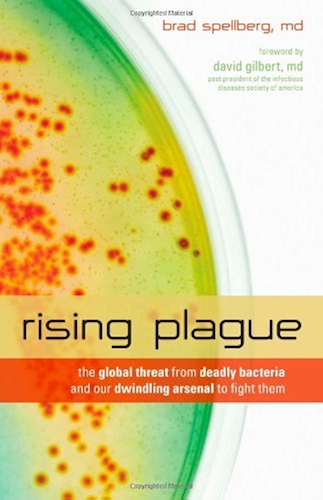

[Télécharger] Rising Plague: The Global Threat from Deadly Bacteria and Our Dwindling Arsenal to Fight Them (English Edition) de Brad Spellberg Pdf Ebook
Télécharger Rising Plague: The Global Threat from Deadly Bacteria and Our Dwindling Arsenal to Fight Them (English Edition) de Brad Spellberg Livres En Ligne
Télécharger "Rising Plague: The Global Threat from Deadly Bacteria and Our Dwindling Arsenal to Fight Them (English Edition)" de Brad Spellberg Livre PDF Gratuit
Auteur : Brad Spellberg
Catégorie : Boutique Kindle,Ebooks Kindle,Ebooks en langues étrangères
Broché : * pages
Éditeur : *
Langue : Français, Anglais
Antibiotic-resistant microbes infect more than 2 million Americans and kill over 100,000 each year. They spread rapidly, even in such seemingly harmless places as high school locker rooms, where they infect young athletes. Throughout the world, many more people are dying from these infections. Astoundingly, as antibiotic resistant infections are skyrocketing in incidence—creating a critical need for new antibiotics—research and development of new antibiotics has ground to a screeching halt!In Rising Plague, Dr. Brad Spellberg—an infectious diseases specialist and member of a national task force charged with attacking antibiotic resistant infections—tells the story of this potentially grave public health crisis. The author shares true and very moving patient stories to emphasize the terrible frustration he and his colleagues have experienced while attempting to treat untreatable infections, not to mention the heart-break and tragedy that many of these patients’ families had to endure. Dr. Spellberg corrects the nearly universal misperception that physician misuse of antibiotics and "dirty hospitals" are responsible for causing antibiotic-resistant infections. He explains the true causes of antibiotic resistance and of the virtual collapse of antibiotic research and development. Most important, he advocates ways to reverse this dire trend and instead bolster the production of desperately needed new and effective antibiotics. He also warns against complacency induced by the decades-old assumption that some miracle drug will always be available to ensure the continuation of our "antibiotic era." If we do nothing, we run the risk of inviting a bleak future when infectious diseases will once again reign supreme. Then many of the medical breakthroughs that we now take for granted—from routine surgery and organ transplants to intensive care and battlefield medicine—might all be threatened. This crucial and timely book is lucidly written in terms that everyone can understand. It issues a call to action, explaining how, through a strong and concerted effort, we can all help prevent this nightmare scenario from happening. By following this courageous doctor’s recommendations, we can assure that magic bullets will be there for our families and us in the future.
Télécharger Rising Plague: The Global Threat from Deadly Bacteria and Our Dwindling Arsenal to Fight Them (English Edition) de Brad Spellberg Francais PDF
PDF Drive - Search and download PDF files for free. ~ PDF Drive is your search engine for PDF files. As of today we have 75,988,224 eBooks for you to download for free. No annoying ads, no download limits, enjoy it and don't forget to bookmark and share the love!
Sous-titres.eu – Sous-titres de films et séries TV ~ Téléchargement de fichiers sous-titres français et anglais de séries TV et de films VO - sous-titres.eu
Plague Inc. - Apps on Google Play ~ Can you infect the world? Plague Inc. is a unique mix of high strategy and terrifyingly realistic simulation. Your pathogen has just infected 'Patient Zero'. Now you must bring about the end of human history by evolving a deadly, global Plague whilst adapting against everything humanity can do to defend itself. Brilliantly executed with innovative gameplay and built from the ground up for .
Uloz.to ~ Uloz.to is the largest czech cloud storage. Upload, share, search and download for free. Credit allows you to download with unlimited speed.
APKPure APK Downloader for Android Wear, Phones, Tablets, TV ~ APKPure offers a selection of the best Android games and apps which you can not even find them in Play Store search results. No region lock worries. Download and play now for free. Safe Downloading . All Apps in the APKPure are safe for your Android phone to download. They have to pass a signature verification check before they are listed in APKPure. Multi-language Supported. APKPure mobile .
Home / Games Workshop Webstore ~ Enter your email to get the very latest - news, promotions, hobby tips and more from Games Workshop. You can unsubscribe at any time. By subscribing you confirm that you are over the age of 13 or have consent from your parent or guardian to subscribe.
Play Dauntless / Dauntless ~ Dauntless is a free-to-play co-op action RPG available for Nintendo Switch, PlayStation 4, Xbox One, and PC on the Epic Games store.
Google Traduction ~ Ce service gratuit de Google traduit instantanément des mots, des expressions et des pages Web du français vers plus de 100 autres langues.
The Economist - World News, Politics, Economics, Business ~ In late March, 80% of our articles mentioned “covid” or “coronavirus” Podcasts Sound reasoning on current affairs, business and finance, science and technology, and global issues.
New Scientist / Science news and science articles from New ~ Wombling, boojums and thunk: Test yourself in our jargon-busting quiz. As 2020 ends, vaccines give us a shot at returning to normal life Leader. Health Jupiter Saturn conjunction: How to see .
Saving Earth / Saving Earth / Encyclopedia Britannica ~ 2020 marks the 50th anniversary of Earth Day and is the start of a critical decade in the fight to save our planet’s health. Learn about what we’ve accomplished and failed to accomplish in the last 50 years, and explore some of the key environmental problems we still have yet to solve. Learn about the promising solutions that do exist for these challenges, meet the figures and .
myCANAL : tv, sports, séries, films en streaming en direct ~ Regarder les meilleurs programmes, films, séries, sports en streaming direct ou en replay. Le programme TV de toutes les chaines est gratuit et sans pub.
Funko ~ <img height="1" width="1" border="0" alt="" src="https://s.amazon-adsystem/iui3?d=forester-did&ex-fargs=%3Fid%3D55fd4f89-c392-a04f-edf6-6eb60f20180f%26type .
Brainly - For students. By students. ~ Post your questions to our community of 350 million students and teachers. Get expert, verified answers. Learn faster and improve your grades
Free Flip Book Maker; PDF to HTML5 & Flash flipping book ~ Create a completely immersive point & click shopping environment with our easy-to-integrate service solution. Allows your viewers to shop directly from your digital catalog/magazine without leaving the page. Learn more. Table of Contents. Create a multi-level table of contents directly in AnyFlip's user-friendly interface, or import them automatically from PDF documents. The table of contents .
Wattpad - Where stories live ~ Wattpad connects a global community of 90 million readers and writers through the power of story. . unsigned, and talented writers on Wattpad and connects them to global multi-media entertainment companies. Wattpad Studios works with partners such as: Your voice belongs on bookshelves. Wattpad Books aspires to recognize and reflect diverse voices by taking Wattpad stories to published book .
BBC - Homepage ~ Breaking news, sport, TV, radio and a whole lot more. The BBC informs, educates and entertains - wherever you are, whatever your age.
Discover the Best eBooks, Audiobooks, Magazines, Sheet ~ Download our app to read books on any device. Follow Scribd on Twitter; Like Scribd on Facebook; Follow Scribd's profile; Endless entertainment and knowledge. Read or listen anytime, anywhere. Read free for 30 days. Only $9.99/month after. Cancel anytime. Membership Benefits. Books. Audiobooks. Magazines. Podcasts. Sheet Music . Documents. Scribd vs. other subscriptions *Access an unlimited .
Tier List Maker for Everything - TierMaker ~ There are already 200,000+ tier list templates available on TierMaker and you can make a tier list for nearly anything by searching for the topic you are interested in or starting on our category page. You use our tier list maker to quickly create your own, unique and interactive template that anyone can use.
Quora - A place to share knowledge and better understand ~ Quora is a place to gain and share knowledge. It's a platform to ask questions and connect with people who contribute unique insights and quality answers. This empowers people to learn from each other and to better understand the world.
Google Translate ~ Google's free service instantly translates words, phrases, and web pages between English and over 100 other languages.
Home - BBC News ~ Visit BBC News for up-to-the-minute news, breaking news, video, audio and feature stories. BBC News provides trusted World and UK news as well as local and regional perspectives. Also .
Livres sur Google Play ~ Profitez de millions d'applications Android récentes, de jeux, de titres musicaux, de films, de séries, de livres, de magazines, et plus encore. À tout moment, où que vous soyez, sur tous vos appareils.
Dictionary, Encyclopedia and Thesaurus - The Free Dictionary ~ The World's most comprehensive free online dictionary, thesaurus, and encyclopedia with synonyms, definitions, idioms, abbreviations, and medical, financial, legal specialized dictionaries
The Lighter Side of Science / IFLScience ~ We're here for the science - the funny side of science. Quotes, jokes, memes and more. We're dedicated to bringing the amazing world of science to you!
Comments
Post a Comment